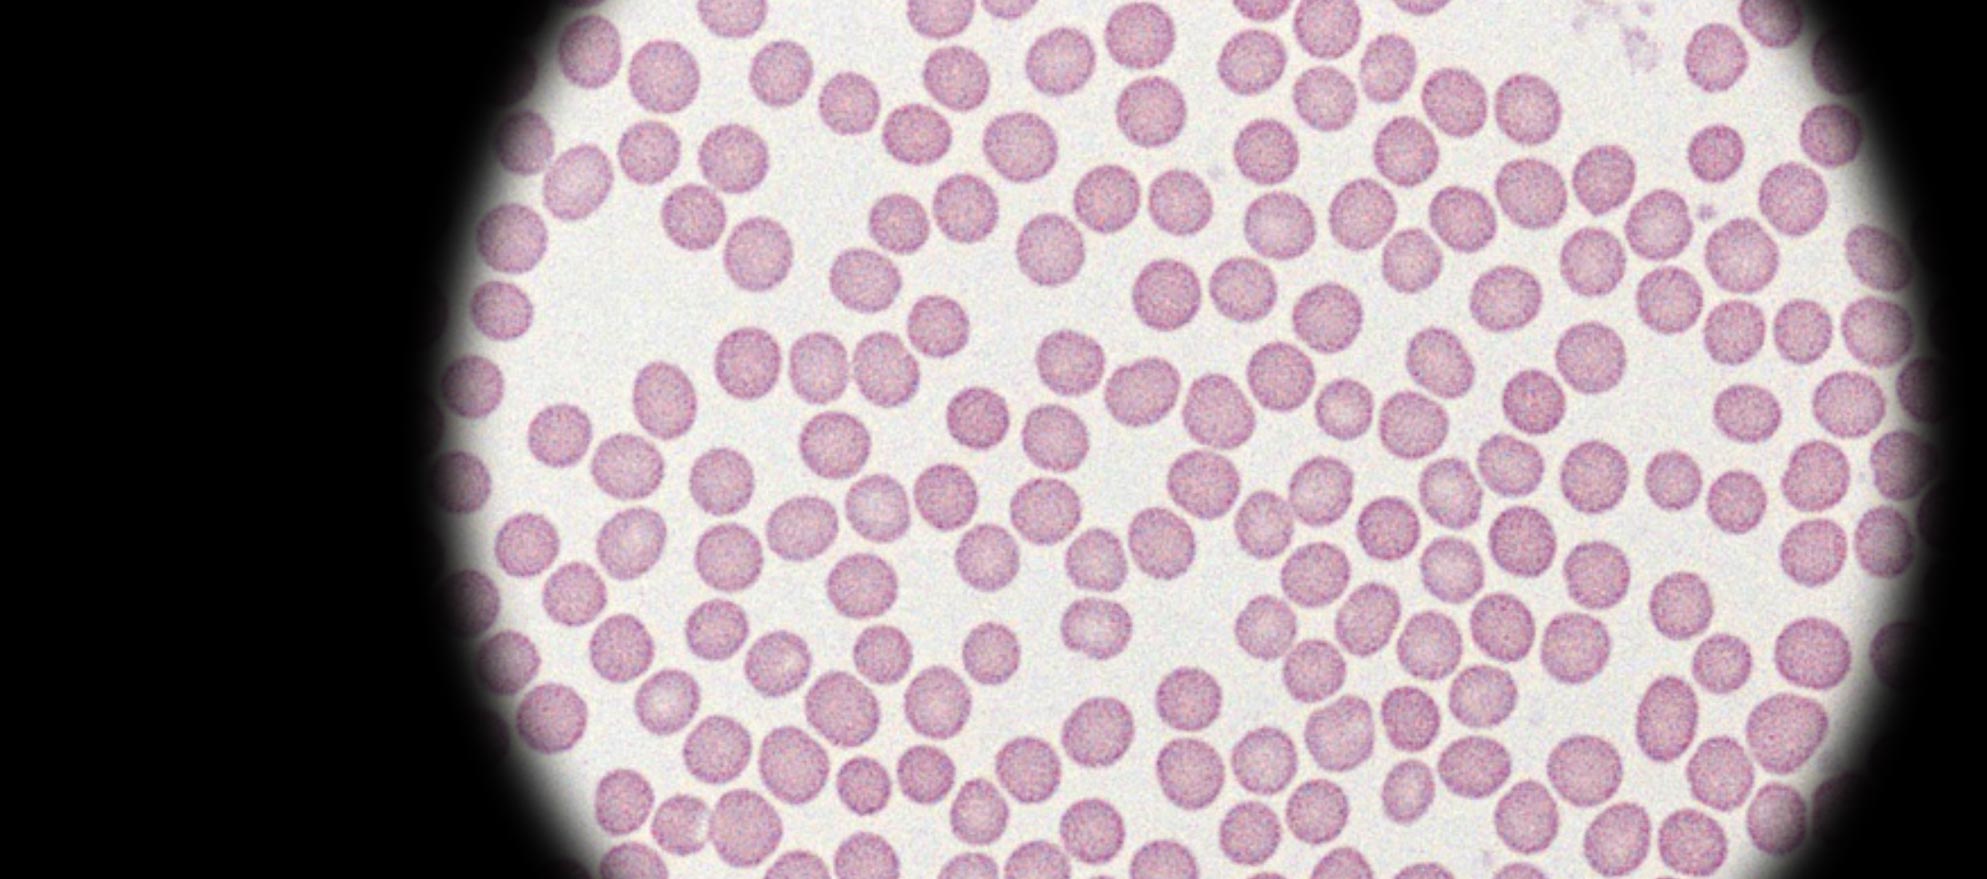
term image

Module 3: Function of Cell Membranes
1/25
There's no tags or description
Looks like no tags are added yet.
Name | Mastery | Learn | Test | Matching | Spaced | Call with Kai |
|---|
No analytics yet
Send a link to your students to track their progress
26 Terms
Filtration
A process in which fluid is forced through a selectively permeable membrane
Diffisuion
Net movement of particles from a place of higher concentration to a place of lower concentration due to constant spontaneous motion
Simple Diffusion
How oxygen and CO2 diffuse
Facilitated Diffusion
How glucose and ions diffuse
Osmosis
The net flow of water from one side of a selectively permeable membrane to another
In osmosis water flows from the — watery side to the — watery side
more, less
Tonicity
The ability of a solution to change the volume or pressure of a cell by osmosis
Isotonic Solution
The extracellular fluid and cytosol have the same relative concentration of solutes and there’s no net movement of water through the plasma membrane
Hypotonic Solution
The concentration of solutes in the extracellular fluid is lower the the cytosol and water moves into the cell increasing pressure until it bursts
Hemolysis
Rupturing of red blood cells
Hypertonic Solution
The concentration of solutes is greater in extra cellular fluids then the cytosol and water moves out of the cell reducing pressure and volume until it shrinks
Crenation
Water volume in the cell reducing until the cell shrinks

Hypotonic Cell
Normal Cell

Hypertonic Cell
Benedict Solution
Used to detect reduction in sugars
Iodine Solution
Tests for presence of starch
Silver Nitrate Solution
Detects salt if theres a cloudy streak theres salt

No reducing sugars

Moderate sugar level

Low Sugar (higher then green)

Traceable sugar

High Sugar Level
Water Soluble Substances Need — or — to Diffuse
Protein Chanel or Pore
Active Transport
Substances move against the gradient from low to high cincetration